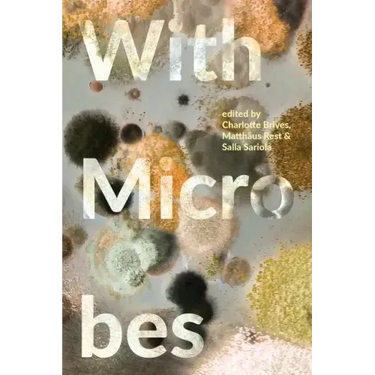
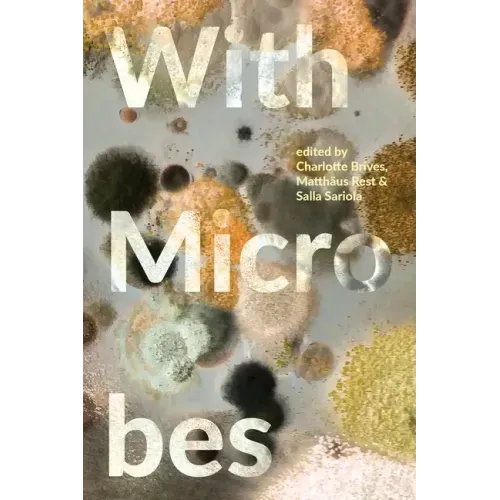

With Microbes - Paperback
With Microbes - Paperback
$37.24
/

products.product.pickup_availability.unavailable
Your payment information is processed securely. We do not store credit card details nor have access to your credit card information.
by Charlotte Brives (Editor)
Without microbes, no other forms of life would be possible. But what does it mean to be with microbes? With Microbes sets microbes and the multiple ways they exist around, in and on humans at center stage. In this book, 24 social scientists and artists attune to microbes and describe their complicated relationships with humans and other beings.
The book shows the multiplicity of these relationships and their dynamism, through detailed ethnographies of the relationships between humans, animals, plants, and microbes. Ethnographic explorations with fermented foods, waste, faecal matter, immunity, antimicrobial resistance, phages, as well as indigenous and scientific understandings of microbes challenge ideas of them being simple entities: not just pathogenic foes, old friends or good fermentation minions, but so much more. By describing these complex, dynamic, and ever-changing entanglements between humans and microbes, the chapters raise crucial points about how microbes are 'known' and how social scientists can study microbes with ethnographic methods, more often than not in the absence of microscopes, models, and computations. Following these various entanglements, the book tells how these relations transform both humans and microbes in the process.